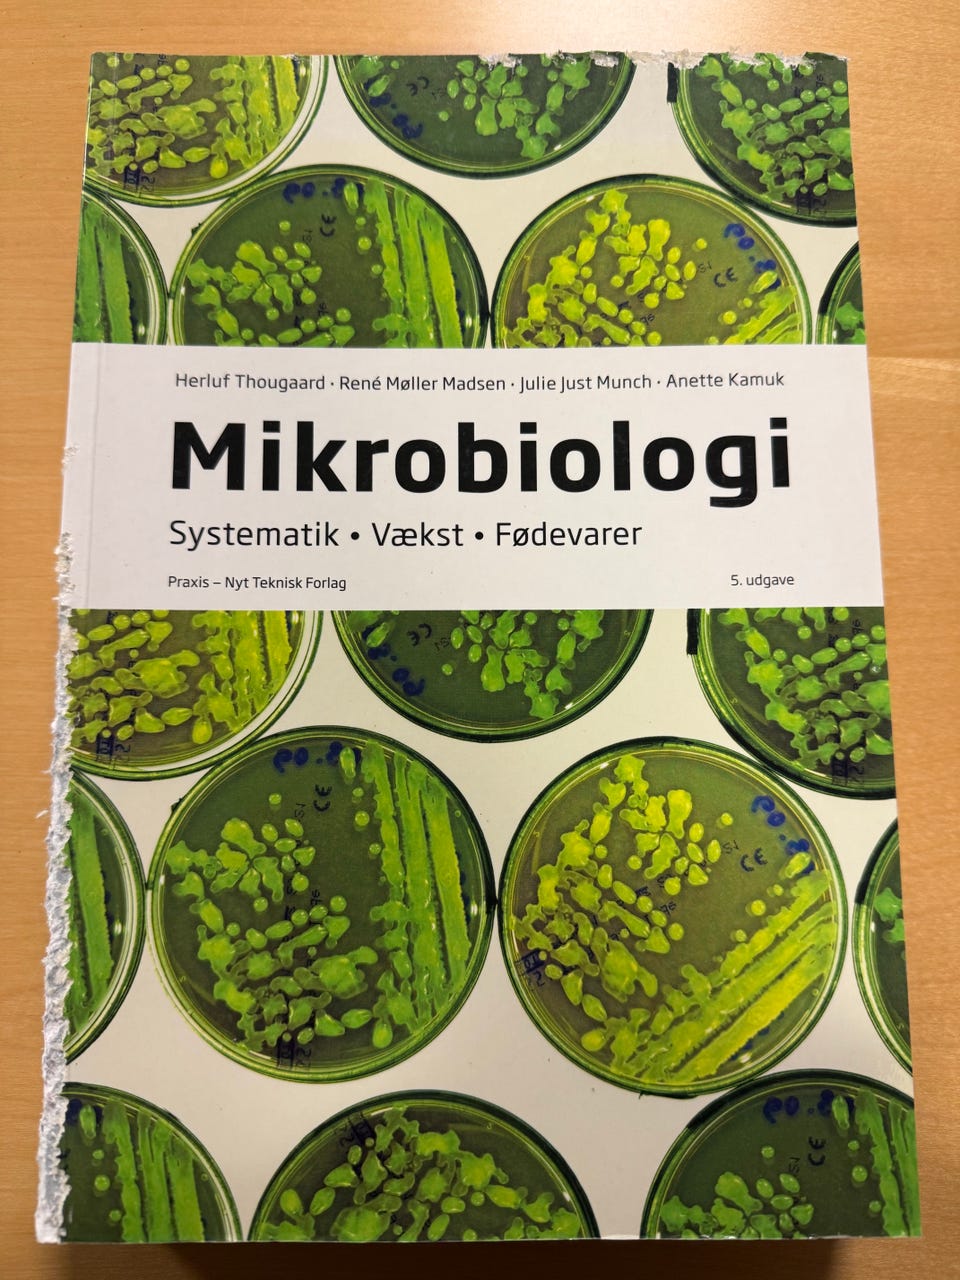
Galleribillede

Billedgalleri
Laborant studiebøger
Til salg
Fragt fra 59,99 kr. + Tryg betaling 63 kr.
Tryg handel med Fiks færdig
Fiks færdig er DBA's nye betalings- og fragttjeneste. Efter levering har du 24 timer til at kontrollere varen, før pengene udbetales til sælgeren.
Varebeskrivelse
Stand: Som ny - ingen synlige brugsspor
Emne: Andre studiebøger
Sælger en komplet samlet pakke med 11 undervisningsbøge til laborant studiet, alle bøgerne er alle nyere udgaver fra Akademisk Forlag og Samfundslitteratur.
Generelt meget velholdte og i pæn stand.
To af bøgerne har desværre blevet gnasket lidt i af min kanin, skaderne er kun kosmetiske (se billede).
Der kan medfølge sikkerhedsbriller, saks og pincet ved interesse (sikkerhedsbriller dog kun ved afhentning).
Molekylærbiologi og biokemi af Bodil Stilling, Inger Dahl Krabbe, Margit Mølgård Hvilsom
Laboratorieberegninger af Ulla Ethelberg
Opbevaring af laboratoriekemikalier af Lene Hjerrild, Hanne Troen, Jørgen Stage Johansen
Praktisk Mikrobiologi af Herluf Thougaard, Verner Varlund, Rene Møller Madsen
Kemiske enhedsoperationer af Preben Hartmann-Petersen
Håndbog for laboratoriefolk af Merete Norsker Bergsøe, Helle Jeppesen
Basis Kemi C af Helge Mygind, Ole Vesterlund Nielsen, Vibeke Axelsen
Basis Kemi B af Helge Mygind, Ole Vesterlund Nielsen, Vibeke Axelsen
Celledyrkning af Vivi Kielberg, Nils Brünner, Per Briand
Mikrobiologi af Herluf Thougaard, René Møller Madsen, Julie Just Munch, Anette Kamuk
Kan sendes på købers regning
Brugerprofil

Du skal være logget ind for at se brugerprofiler og sende beskeder.
Log indAnnoncens metadata
Sidst redigeret: 23.1.2026 kl. 19:26 ・ Annonce-ID: 17702166